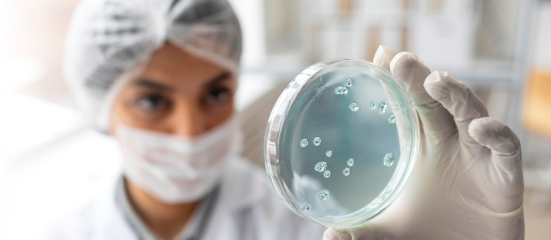
Chimeric Antigen Receptor (CAR) T-cell Therapy

CAR T-cell Therapy
Overview
What is Chimeric Antigen Receptor (CAR) T-cell Therapy?
T-cells or T-lymphocytes are a type of white blood cells in our immune system. T-cells have the capacity to recognise abnormal cells or any cells infected by viruses in the body, and then destroy these abnormal cells.
Chimeric Antigen Receptor (CAR) T-cell therapy is a form of immunotherapy where T-cells are taken from the patient’s blood and modified in a laboratory setting to enable the T-cells to identify and destroy specific cancer cells. The modified T-cells are then reinfused into the patient. Once back inside the patient’s body, the modified T-cells will be able to detect the cancer cells and destroy the cancer by harnessing the body’s own immune response.

Singapore is the first country in Southeast Asia to offer the treatment^.
^Source: CNA
What conditions can it treat?
CAR T-cell therapy is particularly effective for patients diagnosed with relapsed or refractory B-cell Acute Lymphoblastic Leukemia (B-ALL); Aggressive B-cell Non-Hodgkin Lymphoma and Multiple Myeloma.
Who is eligible?
Selected groups of patients are eligible for CAR T-cell therapy. They include:
- Children and young adult patients from 2 to 25 years old with B-cell Acute Lymphoblastic Leukemia (ALL) that is resistant, and where a relapse has occurred subsequently or post-transplant.
- Adults with relapsed or refractory aggressive B-cell Lymphoma who have not benefited from at least one or two types of standard treatment.
- Adults with relapsed or refractory Multiple Myeloma who failed one or two prior therapy.
- Patients with intracranial hypertension or unconsciousness
- Patients with respiratory failure
- Patients with disseminated intravascular coagulation
- Patients with hematosepsis or uncontrolled active infection
Receiving CAR T-cell Therapy
How does it work?
The patient will first undergo assessment and some investigations to determine if CAR T-cell therapy is an appropriate treatment option for their disease, and to ensure that the patient is fit to undergo treatment.
Step 1. Collecting the T-cells
White blood cells, which include T-cells, will be extracted from the patient’s blood using a procedure called leukapheresis. During this procedure, two intravenous infusion (IV) lines will be inserted into the patient: blood is extracted through one line, to allow the white blood cells to be separated out and extracted, while the rest of the blood is returned to the patient’s body through the second line.
Step 2. Making the CAR T-cells
After the white blood cells have been extracted, the product will be sent to the laboratory where T-cells will be separated out to be altered. This alteration is carried out by adding the specific Chimeric Antigen Receptor (CAR) gene to the T-cells, hence modifying them into CAR T-cells. These cells will then be grown and multiplied in the laboratory.
Under normal circumstances, it can take 2–3 weeks to produce the adequate number of CAR T-cells required for CAR T-cell therapy.
Step 3. Receiving the CAR T-cell Infusion
After CAR T-cell production has been completed, the produce will undergo stringent quality control assessment before shipping back to the hospital to be infused into the patient.
A few days prior to the CAR T-cell infusion, the patient may be given gentle chemotherapy to prepare the body to receive the CAR T-cells. This provides the newly infused CAR T-cells a better chance to be ‘activated’ to fight the cancer. Generally, the chemotherapy is less intense to ensure there are cancer cells remaining for the CAR T-cells to ‘activate’ effectively.
Once the CAR T-cells begin binding with cancer cells in the body, they will begin to increase in number and destroy even more cancer cells.
Step 4. Recovery
Patients receiving CAR T-cell therapy will have an early recovery period of approximately 3–4 weeks before they can be discharged. During this period, patients will be monitored for any side effects and assessed on treatment response.
What does the recovery process look like?
Patients will be admitted for the first 3-4 weeks to monitor from any side effects of CAR T-cells treatment before they are allowed to go home.
Following discharge, patients will have to go for regular outpatient appointments to monitor side effects and clinical responses to treatment. Recovery typically takes 2–3 months from the CAR T-cell infusion.
Side Effects of CAR T-cell Therapy
What are the side effects?
One common side effect of CAR T-cell therapy is Cytokine Release Syndrome (CRS), which is a multisystemic disease resulting from the effects of CAR T-cells at work and elimination of cancer cells.
Symptoms of CRS include:
- High fever and chills
- Difficulty breathing
- Nausea, vomiting and/or diarrhoea
- Feeling dizzy and lightheaded
- Headaches
- Fast heartbeat
- Fatigue
- Muscle and/or joint pain
CRS usually develops within two weeks after infusion, although rare cases occurring many weeks later have been reported. The severity of CRS is not correlated with the response to CAR T-cell therapy.
Another common side effect is immune effector cell-associated neurotoxicity syndrome (ICANS), which affects the central nervous system of the patient.
Symptoms of ICANS include:
- Headache
- Changes in consciousness
- Confusion
- Seizures
- Tremors or twitching
- Difficulty speaking
- Loss of balance
CRS and ICANS are well recognised side effects that are highly treatable and can be managed by a trained clinical care team.
Benefits & Challenges
What are the benefits and challenges?
CAR T-cell therapy offers patients with blood cancers a potential lifesaving treatment option in the event that their disease is not controlled by standard chemotherapy, targeted therapy or bone marrow transplantation.
However, as it is a relatively new area of cell therapy, there are some challenges to consider such as the selection of patients who will benefit from this treatment, their level of medical fitness, the timing of cell collection, logistical concerns, and the risk–benefit ratio of treatment for the individual patient.
Frequently Asked Questions (FAQ)
CAR T-cell therapy has shown promising outcomes for the treatment of lymphoma and other blood cancers.
The overall success rate in achieving complete remission with CAR T-cell therapy is 40–60% for lymphomas and 70–80% for leukemias.* Many patients with previously relapsed blood cancer have shown promising responses with no evidence of cancer after treatment. Durable long-term remissions are achievable for patients who respond to therapy. Among responders, approximately 65–80% remained disease-free at 2 years, and around 40% remain alive at 5 years.*
CAR T-cell therapy brings hope to patients whose diseases have failed to respond to most traditional cancer therapies. Currently, newer generations of CAR T-cells are being developed and researched, including third-generation CAR T-cells, dual target CAR T-cells, and allogeneic CAR T-cells. These developments will further improve efficacy while reducing side effects.
*Source: ASH Publications and PubMed Central® (PMC)
Yes, the survival advantage of CAR T-cell therapy is better than conventional chemotherapy and autologous stem cell transplantation in certain conditions, such as, relapsed/refractory aggressive B-cell Lymphoma, B-cell Acute lymphoblastic Leukemia and Multiple Myeloma. CAR T-cell therapy offers improved life expectancy compared to conventional chemotherapy, especially in relapsed/refractory blood cancers.
CAR T-cell therapy is a revolutionary therapy with high success rates. The field is expanding beyond haematology, with ongoing clinical trials worldwide investigating CAR T-cells in solid tumours and autoimmune disease.
